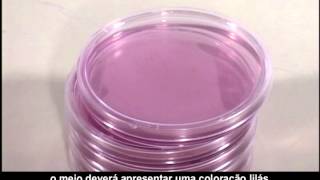
Investigação de micro-organismos por meio de cultivo e observação de fungos e bactérias

Videoaula 1 - Preparo de Meio de cultura
34.47k views1060 WordsCopy TextShare

Fernando Freitas
Videoaula realizada para o componente Ações Microbiológicas na Água, Ar e Solo. Curso Técnico em Mei...
Video Transcript:
e aí o olá cara uma estamos aqui no lado e para fazer uma aula prática para vocês dentro do componente ações microbiológicas da água no ar um só então em aulas teóricas vocês viram um pouco da importância do meio de cultura do cultivo de bactérias e outros microorganismos em laboratório o e nessa hora mas vamos falar justamente disso dos meios e cultura que são eco rosto né que a gente tem meio de cultura eles são compostos é que envolvem lá que tem um conjunto de nutrientes que são necessários para o crescimento cultivo dos microrganismos em
laboratório o meio que nós vamos trabalhar hoje eu te s.a. que é um mês e cultura bastante remédio que dá a possibilidade de crescer uma série de microrganismos tá então assim nós temos aqui é o meio de cultura já em pó tá e aqui na nessa nessa embalagem nós temos uma receitinha que mostra como preparar esse e-mail então nós vamos seguir aqui a receita vamos pesar quantidade de se meio de cultura e depois vamos diluir em água e tá bom então vou apresentar aqui o material que nós vamos usar na hora de hoje então temos
aqui a água destilada a vamos usar 500 ml de água destilada temos aqui um cadinho de porcelana para pesar o meio de cultura temos aqui as placas de petri as placas de petri que nós vamos usar né é são de vidro tá então placas de petri de vidro e o meio de cultura e é o ps a carga conectando acessório é aqui nós temos a balança vamos usar a palavra para fazer a pesagem do meio e temos aqui também o agitador magnético porque a diluição nesse meio de cultura ela deve ser feita com água aquecida
para que ocorra a melhor definição aí possível dormir ponto importante sempre no laboratório é a utilização de luvas né duas urso eles são relativos aos a minhas roupas oi e aí o a próxima etapa que nós vamos já desenvolver aqui é o aquecimento da água nós vamos deixar a água que sem eu tenho aqui um frascos choque de 500 ml e aqui o agitador magnético que ele também tem essa opção de aquecimento então aqui é o equipamento ele vai aquecer a água e vai me ajudar também a diluir aqui e vou começar deixar ele agitação
m aquecimento enquanto vai acrescentar água nós vamos fazendo lá pesado então vem aqui pertinho de porcelana né e que o valor de um peso e eu vou fazer o zerar tô fazendo aqui cara só que temos o meio de cultura nós vamos fazer metade da receita do rótulo tá então metade da receita aqui vem uma receita para 40 gramas de meio de cultura para 1l então nós vamos fazer metade da respeito nos pesados 20 gramas de si e aí e aí o ponto 9 então e agora vamos lá água já tá praticamente aqui no ponto
de cerveja tatu de 90 graus 95 graus aqui bom então nós vamos fazer aqui a mistura do meio de cultura com a água água então agora o próximo passo e levar esse fraco para autoclave uma vez que é um meio de cultura que não é stereo né então é necessário agora uma etapa na autoclave as nossas placas de petri elas foram lavadas foram secas mas ainda não foram esterilizados então vamos fazer aqui uma embalagem com papel kraft e fita crepe que vai junto com meio de cultura para autoclave para nós vamos colocar aqui o material
dentro da autoclave autoclave aqui ó ó e como colocar esse material aqui condicionar ele da forma e talvez material já posicionadas nós vamos fechar nós vamos fazer aqui o fechamento da autoclave o concurso há cerca de um lado a outro tá g1 e aí oi e aí vamos colocar a chave comutadora no máximo e aguardar aqui no manômetro chegar a 121° e aí o material ficou 15 minutos autocaravana 120° depois nós colocamos a chave comutadora é se desligamos né depois desse tempo e é muito importante e esperar o meu número vou tá ali para o
zero então quando chegou no zero aí nós abrimos essa válvula para tirar toda a pressão agora o material já tá pronto oh e vamos transferir esse material que tá autoclavado já está esterilizado para o fluxo laminar onde nós vamos ver ter o meio de cultura nas placas de petri o material resultado da autoclave foi colocado dentro do fluxo laminar e funciona ali com uma cortina de vento impede a entrada dos microrganismos e foi previamente esterilizado por uso ver e agora nós partilhamos que o procedimento de verter queimei esperar esfriar um pouquinho que ia ter aquele
e-mail nas placas e peças então aqui nós temos já foram desembala água certo eu até usei papel kraft para isolar um pouco aqui o calor para poder pegar é claro que esperou esse é um pouquinho e veio lá com 120 graus e agora nós vamos abrir g1 e eu já falei aqui pra si só vamos ver que o meio dentro das placas e aí eu vou colocar só uma quantidade a conta dele é espalhar ali pela fala é uma coisa a gente já tem pronto a gelatina ou larga e não deu choque pra hoje nós
vamos fazer isto sucessivamente vamos abrir a placa ou calma de pintura ó até ele tomar conta totalmente a placa de petri eu vou tirar vou deixar para fazer a endurecimento esfriar e aí vamos grossão essa forma de proceder com todas as placas esse volume parecida [Música] e aí é bom pessoal nessa aula nós demonstramos como preparar o meio de cultura sólido no seu passo a passo então vocês verificaram o preparo a necessidade de realizar a esterilização esse meio de cultura e esse meio de cultura sólido ele tem o h na sua composição então ele vai
ter depois da consistência de gelatina em uma próxima aula vocês viram a utilização dessas placas de petri para semeadura de amostras ambientais e o crescimento de bactérias nessas placas é possível utilizar essas placas agora para contagem de bactérias para isolamento de colônias então isso vai ficar com o próximo vídeo aguardo vocês nessa próxima tela nós e aí
Related Videos

11:50
MEIOS DE CULTURA EM MICROBIOLOGIA - PROF. ...
Alexandre Funck
45,648 views

20:25
Videoaula 2 - Semeadura e crescimento de m...
Fernando Freitas
14,980 views

6:03
COMO É FEITO O PREPARO DE MEIO DE CULTURA ...
Renata Aquino - Do Básico ao Clínico
38,535 views
9:15
Investigação de micro-organismos por meio ...
Laboratório de Tecnologias Educacionais
200,481 views

56:13
Preparo de meio de cultura
Dra. Carla Leite - Vídeos de Microbiologia
12,851 views

45:08
Aula Pratica 1 - Material e técnicas util...
Caio Rachid
14,965 views

59:46
Preparação de meios de cultura em placas d...
PROF. MAYER
26,249 views

1:05:32
Aula 7 Cultivo Celular
Deisy Resende
5,095 views

4:56
Semeadura em tubos
ConectaMicroUFF
9,783 views

1:47
Microbiologia - Cultivo de microrganismo e...
Kasvi - Produtos para Laboratório
110,917 views

21:27
Coloração de Gram | aula prática
PROF. MAYER
22,330 views

25:17
Microbiologia de Alimentos: Técnica de Pla...
Prof Marina Copetti
15,918 views

28:52
Métodos Analíticos de Microbiologia de Ali...
Cris Zaicovski
38,328 views

5:59
TÉCNICAS DE SEMEADURA EM MEIO SÓLIDO, NA P...
Renata Aquino - Do Básico ao Clínico
27,487 views

40:32
Microbiologia Médica: Principais Meios de ...
CS Ciências da Saúde
26,785 views

47:16
Microbiologia - Meios de Cultura
Camila de Souza
5,905 views

10:16
Microbiologia - Técnica de Antibiograma
Jaqueline Scapinello
9,405 views

23:37
Coloração de Gram - Aula completa - Prof. ...
Felipe Magalhães
53,813 views

19:22
Métodos Analíticos de Microbiologia de Ali...
Cris Zaicovski
40,282 views

9:00
Meios de Cultura Bacterianos
Mundo Microscópico
10,059 views